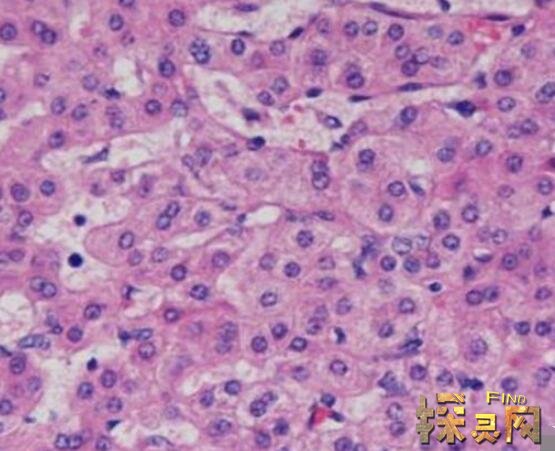

世界上有着千奇百怪的病症,这对于医学界来说是一个全新挑战。最近在杭州萧山一个医院中发生了这样一件离奇病例,当时一位护士在怀孕后竟然得了吸血鬼病。这种病大家一定闻所未闻,因为非常罕见,全球仅仅只有几百例。下面就来揭秘一下杭州护士吸血鬼病事件真相。
杭州护士吸血鬼病事件盘点

事件发生在2019年5月1日,当时一位杭州萧山护士前去医院就诊,其就诊病因就是在怀孕一个月时间内出现肚子疼痛、突发中风症状。然而在中风经过手术治疗后依然没有缓解,病情越来越严重,行为举止异常、精神错乱。

于是专科医生们又进一步作了分析,将病人一些病情进行梳理,如敏感、精神异常、游走性腹痛。并将病人的尿液放在阳光下暴晒4个小时,其观测到尿液变为咖啡色。这些种种因素加在一起,医生们断定这位病人得了吸血鬼症,在医学上称之为卟啉病。

据资料显示这种病只在教科书上存在,而在现实中没有发生过。当病人得了吸血鬼症后,就会非常惧怕阳光,出门不打伞易至皮肤晒伤进而出现水泡瘙痒。据病例资料显示,这种病仅有5万分之一发率,且女性发病多于男性,据统计全球仅有500例这样病症。
卟啉病导致原因
这种病是一种常染色体显性遗传疾病,所以和家族有一定必然联系。据医学介绍直系亲属有50%的概率携带有该变异,继而有50%的概率将疑似致病基因传给其子女。据这位护士父母透露,父母属于表兄妹关系是近亲结婚,所以导致女儿出现基因变异得了卟啉病。
卟啉病特点

卟啉是一种光敏色素,大多数卟啉在避光中呈良性,不会对身体造成生命危害,一旦接触阳光会转化成危险的毒素,如果皮肤受到影响,日光下会发生水泡或瘙痒。只能生活在黑暗世界里,惧怕阳光,这可能是吸血鬼故事的起源。
卟啉病治疗方法

目前在医学上这种病没有根治办法,一般都是补充患者身体缺乏的血红素。对于女性患者,有的医生主张用药终止月经来减少失血,也就保住了血红素,但这样对正常的生理代谢影响太大。目前国内医院多用氯丙嗪减轻腹痛并控制精神症状。
-
张三丰是一位具有传奇色彩的人物,关于它的塑造在各个版本电视剧中均有体现,他开创了武当派成为了武当祖师,在武功造诣上登峰造极,创立了太极拳,以至于现在许多广场都在练...
2019-05-09
-
世界上有很多令你无法想象事情,或许你可以认为根本不可能却变为可能,正如李宁品牌那句一切皆有可能。今天本问要讲述是一个国家—泰国,对于这个国家最为盛名就是人妖了。可...
2019-05-08
-
说起731部队,广大的中国同胞是深恶痛疾的,它在抗日战争和第二次世界大战期间不知道残害的多少中国人,是日本法西斯侵略东北阴谋发动细菌战争期间屠杀中国人民的主要罪证之一...
2018-07-18
-
还记得2012年的周小玲辣条尸油事件吗?那几年的食品安全问题闹得沸沸扬扬的,而用尸油加工食品也成了全国人民关注的对象,毕竟食用尸油可不是一件小事。据说周小玲的辣条是用尸...
2018-02-23
-
云顶天宫是盗墓笔记中的一座天墓,按常理来说在现实生活中是不可能存在的,但是近期却在网上流传出有人在飞机上拍到了天宫,这个消息传出去之后,不少人都为之惊呆,没想到传...
2018-02-14
-
在2004年,人类天文学家发现了一颗小行星直奔地球而来,预计在2036年与地球交锋,有二十五万分之一的几率与地球相撞,别看这个几率小,在天文上这已经是非常可观的数字了。人类...
2018-02-09
-
霍金为人类的发展做出了巨大的贡献,所以对于霍金的言论都十分的看重。在2011年霍金在接受美国以访谈节目采访时,对地球的未来做出了五大预言,霍金预言实现过几次呢?目前还没...
2018-02-08
-
在电影《异形》中,有一种外星寄生虫叫做抱脸虫,相信看过这部电影的朋友都被它恶心到了。在现实中,也有一种恶心的外星寄生虫。它们会寄生在鱼类的舌头上,不断蚕食最终取代...
2018-01-18
-
如今,亚特兰蒂斯已经成为了水下世界的代名词,因为在传说中,亚特兰蒂斯大陆在九千年前遭遇了一场自然灾难,使得整个大陆沉入了海底。亚特兰蒂斯真的存在吗!?这已经困扰了考...
2018-01-18
-
泰国是信仰佛教的国度,认为许多东西都是可以为自己带来好运的,除了普遍的佛牌之外,最为盛行的就是泰国镀金婴尸,据说是用婴儿的尸体制造而成的,就像印度的木乃伊一样,用...
2018-01-17